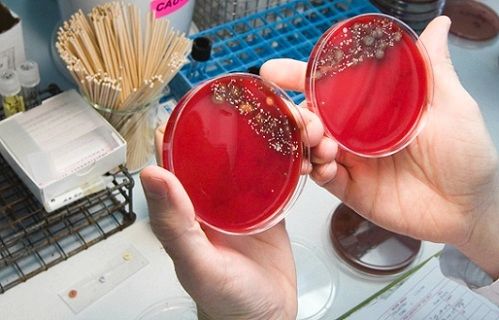

Цистит є наслідком запального процесу сечовидільної системи. Зустрічається в хронічній і гострій стадіях. Причин для виникнення патології безліч, але головні - порушення гігієни і холод.

При циститі для ефективного лікування призначаються препарати різних груп
лікування циститу
Курс лікувальної терапії при запаленні сечового міхура повинен бути комплексним. При гострому періоді призначаються наступні групи препаратів, які потрібно пити при запаленні сечового міхура:
- уросептики (нітрофріновий ряд),
- 1-е покоління антибактеріальної групи,
- цефалоспорини 2 покоління,
- спазмолітики (при сильному болі).
Крім лікарських засобів, призначається збалансоване харчування. Також рекомендується пити багато води. На лікувальний період потрібно відмовитися від алкоголю та інших шкідливих звичок. Для купірування неприємних симптомів рекомендують пити відвари з трав і приймати теплі ванни.
Лікування циститу антибіотиками, особливо хронічного, проходить довго і вимагає декількох курсів з інтервалом в декілька місяців. Її поєднують з крапельним введенням ліків в сечовий міхур.

При відсутності ефекту від препаратів може знадобитися проведення операції
Хронічний цистит - хвороба вторинна. На початку лікувального процесу потрібно визначити і усунути причину, проти якої будуть «працювати» ліки, що володіють широким спектром дії. Це можуть бути камені, бактеріальний вагіноз, інфекції сечостатевої системи, аденома.
При запущеному циститі і його ускладненнях, які не піддаються лікуванню препаратами, призначається хірургічне втручання.
Труднощі в лікуванні
Антибактеріальні препарати на запущеній стадії запалення слід пити тільки після здачі аналізу (бактеріальний посів) і визначення чутливості. Буває, що не у всіх випадках встановлена реакція на антибіотики збігається з «бажаннями» організму.
Якщо лікар неправильно підібрав ліки, то в подальшому виникає стійкість препаратів до певних бактерій. Як правило, антибіотик при циститі перестає допомагати або шкодить здоров'ю людини. Звідси випливає, що правильні результати дуже важливі при постановці діагнозу. Це стосується не тільки лікаря, який трактує урологічні показники, а й людину, від якого вони залежали. Адже до здачі аналізів також потрібно готуватися правильно, інакше одноразово пройти дослідження не вийде.
Для правильно вибору медикаментів необхідно провести аналізи і встановити причини
Лікування антибіотиками проти циститу згубно для здоров'я. Вони токсичні і погано впливають на роботу печінки, шлунка, нирок.
Чим лікувати запалення сечового міхура
Для правильного лікування доктор виписує документ на здачу аналізів, оскільки вони допомагають визначити винуватця захворювання і групу препаратів, що допомагає знищити бактерії. Безліч з усіх ліків мають здатність вилікувати не тільки запалення міхура, а й пієлонефрит з уретритом.
При запущеному запаленні препарати призначаються проти рецидиву хвороби.
Складається в групі хінолінів. Допомагає при наявності грамнегативних елементів і деяких позитивних мікроорганізмів. Основний осад активної речовини залишається в урине. Завдяки цьому застою, запалення зупиняється «на місці».

Ноліцін призначають незалежно від виду захворювання
Ноліцін використовується в лікувальному курсі проти всіх типів циститу. Також він ефективний при пиелите - запаленні ниркової балії. Чоловіки беруть його в разі запущеного простатиту.
Подрібнювати перед вживанням їх не потрібно. Приймають їх за 60 хвилин до трапези або після прийняття їжі. Норму визначає лікар, зазвичай це одна таблетка двічі на добу. При загостренні циститу лікування ноліцін триває три доби, при хронічному - 3 місяці. Пити алкоголь під час лікування заборонено.
Складається в ряді нитрофуранов. Досить ефективний при боротьбі проти грампозитивних і негативних елементів. Засіб використовується для лікування патологічних процесів сечовидільної системи. Також препарат призначається при цистоскопії і катетеризації.
Приймаються таблетки двічі на добу по 0,3 г. У добу для дорослої людини досить 0,6 м При гострому циститі пити препарат потрібно 10 днів. Щоб попередити запалення, Фурадонин застосовується протягом року. Які при цьому потрібно дотримуватися дозування, повинен визначити фахівець.

Застосовувати Фурадонин можна тільки за призначенням лікаря
нитроксолин
Крім купірування грампозитивних мікробів, препарат бореться проти кількох типів грибів. Зазвичай ці ліки не викликає побічних ефектів, рідко можна спостерігати нудоту і незначну алергічну реакцію. З цієї причини Нитроксолин не призначають людям, схильним до алергії, якою б незначною вона не була.
В основі Палина знаходиться піпемідинова кислота, дії якої спрямовані на знищення шкідливої мікрофлори, що сприяє циститу. Антибіотик призначений не тільки проти урологічних захворювань, але і для лікування гінекологічних. Його головний недолік - великий ряд протипоказань. Йдеться про такі побічні ефекти, як:

Палін застосовувати можна після ознайомлення з низкою протипоказань
Лікуємо цистит однією пігулкою
Монурал - порятунок. Відрізняється від аналогів своєю стислістю. Якщо діагностовано цистит в гострій стадії, то досить буде застосування Монуралу одноразово. Щоб відчути ефект, приймається одна таблетка на ніч, після чого спорожняється сечовий міхур. Менше ніж через три години після прийому антибіотика, концентрація препарату досягає максимуму і починаються дії ліки. Людина відчуває відсутність симптомів, настає поліпшення.
Монурал має гідність - безпека. Обумовлюється це висновком ліки з організму в незмінному вигляді. При цьому таблетка не впливає на сторонні органи. Даний факт дозволяє використовувати його жінкам, чоловікам. Можна пити дітям з п'яти років.
У будь-якому випадку таблетка проти запалення призначається фахівцем. Безпека і ефективність підносять Монурал над іншими антибіотиками.
Прийом Монуралу є безпечним для організму
шкода антибіотиків
Лікар завжди повинен пам'ятати про шкоду для здоров'я, коли призначає лікування проти серйозного захворювання. Особливо це стосується антибіотиків. Багато пацієнтів лікуються самостійно, але у випадку з даними препаратами тяга до самолікування згубна.
Антибіотики не є ліками проти всіх хвороб.
Якщо вірусна інфекція - антибіотик не допоможе. Наприклад, при ГРЗ їх прийом марний. Також вони не можуть впоратися з глистами, грибами кандида. Які саме препарати потрібно пити при грипі, скаже терапевт. Як правило, для даного захворювання існують свої таблетки.
Коли прописуються антибіотики при циститі, враховується вік людини, його загальний стан, наявність хронічних хвороб. Ефективність антибіотика залежить від тривалості його прийому. При скороченні лікувального курсу, штами бактерій можуть швидко мутувати. У разі їх довгого прийому високий ризик розвитку дисбактеріозу і алергії. Саме з цієї причини в лікувальний курс включені антигістамінні препарати. Алергічні реакції успішно купіруються супрастином. Також потрібно пити ліки, що сприяють злагодженій роботі кишечника.

Прийом деяких антибіотиків може стати причиною появи нудоти і блювоти
Неприємні наслідки після прийому антибіотиків від циститу можуть проявлятися у вигляді нудоти, блювоти. У жінок провокується зростання грибів в піхву. Вони мають властивість усувати корисні мікроорганізми, які відповідають за захисні сили.
Не рекомендується пити сучасні антибіотики при циститі вагітним жінкам, оскільки вони згубно впливають на дитину. Найнебезпечніший період - перші 7 тижнів. У цей час формується одна важлива річ - плацента. Бажано під час виношування плоду виключити прийом будь-яких лікарських засобів, які б безпечні вони не були.
профілактика
Для профілактики загострення хвороби, жінкам призначаються такі препарати широкого спектру, як:
- ципрофлоксацин,
- нітрофурантоїн,
- норфлоксацин,
- Фосфоміцин.

Дані препарати прописуються в цілях профілактики циститу
Антибіотики при циститі потрібно приймати в певних дозах, їх визначає фахівець. Профілактика триває не менше 6 місяців.
Загострення хронічного циститу спостерігається в кінці весни, початку літа, середині осені. Тому курс профілактики краще проводити саме в ці періоди, адже в ці моменти дії препаратів принесуть максимальну користь. Універсального методу лікування проти хронічного запалення не існує. Лікуючий лікар повинен знайти правильний підхід до лікування, а також врахувати індивідуальні особливості людини, оскільки урологічні захворювання в стадії занедбаності можуть нашкодити стороннім органам.